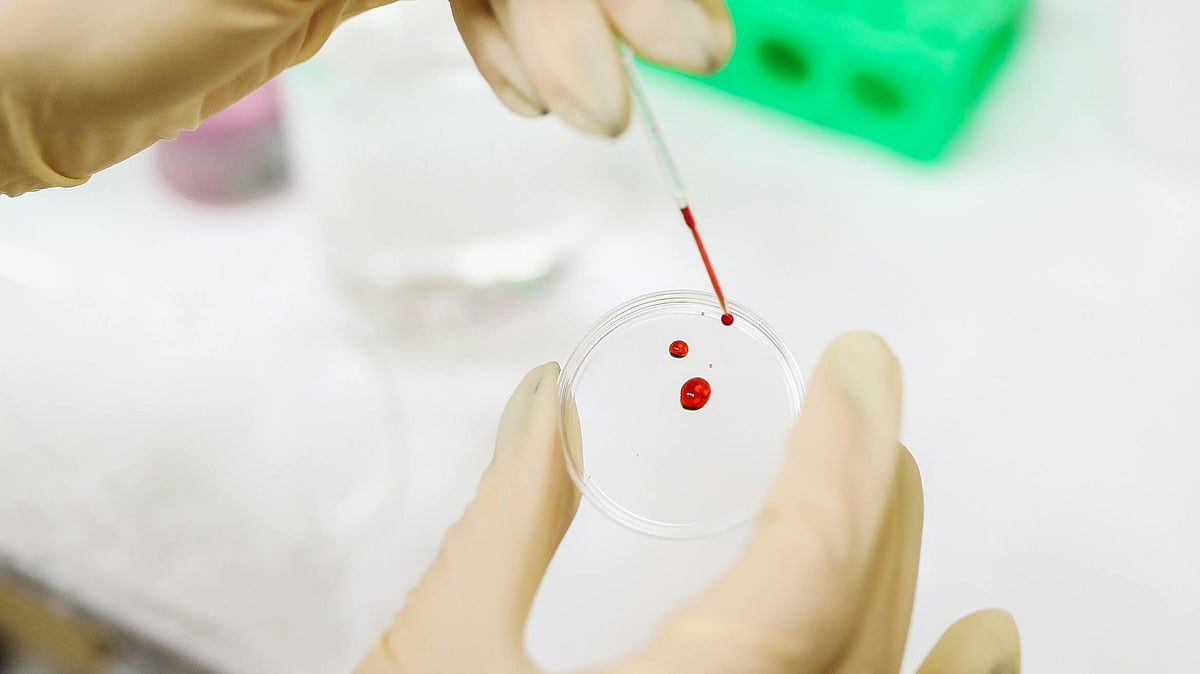
থ্যালাসেমিয়া রক্তের এমন একটি রোগ, যা ক্রোমোজোমের মাধ্যমে বংশানুক্রমে পরিবাহিত হয়

থ্যালাসেমিয়া রক্তের এমন একটি রোগ, যা ক্রোমোজোমের মাধ্যমে বংশানুক্রমে পরিবাহিত হয়। আমাদের দেশের প্রায় ১০ শতাংশ মানুষ এ রোগের বাহক। আগামীকাল ৮ মে আন্তর্জাতিক থ্যালাসেমিয়া দিবস। থ্যালাসেমিয়া সম্পর্কে সঠিক তথ্য জানাচ্ছেন রক্তরোগ, ব্লাড ক্যানসার, থ্যালাসেমিয়া ও বোনম্যারো ট্রান্সপ্ল্যান্ট বিশেষজ্ঞ ল্যাবএইড হাসপাতালের কনসালট্যান্ট ডা. মো. আশিকুজ্জামান
থ্যালাসেমিয়া রোগটিকে দুই ভাগে ভাগ করা হয়ে থাকে। রক্ত পরিসঞ্চালন–নির্ভরশীল এবং রক্ত পরিসঞ্চালন অনির্ভরশীল। রক্ত পরিসঞ্চালন–নির্ভর থ্যালাসেমিয়ায় রোগীকে আজীবন প্রতি মাসে রক্ত পরিসঞ্চালন করতে হয়। এই জ্বালা ভুক্তভোগী ছাড়া আর কারও পক্ষে বোঝা সম্ভব নয়। তাই থ্যালাসেমিয়ার মতো রোগের ক্ষেত্রে প্রতিকারের চেয়ে রোগ প্রতিরোধ উত্তম পন্থা।
নারী-পুরুষ দুজনই থ্যালাসেমিয়ার বাহক হলে তাঁদের যে সন্তান হবে, এর মধ্যে প্রতি চারজনের একজনের এ রোগে আক্রান্ত হওয়ার আশঙ্কা থাকে। তাই এ রোগের ঝুঁকি এড়াতে কিছু বিষয়ে মনোযোগ দেওয়া জরুরি। মোটামুটি তিনটি উপায়ে এই রোগ প্রতিরোধ করা সম্ভব।
বিয়ের আগে রক্ত পরীক্ষা করাতে হবে। দুজনই বাহক হলে তাঁদের মধ্যে বিয়ে রোধ করে পরবর্তী প্রজন্মের থ্যালাসেমিয়া প্রতিরোধ সম্ভব।
স্বামী-স্ত্রী দুজনই যদি থ্যালাসেমিয়ার বাহক হন, তাহলে গর্ভাবস্থায় কিছু প্রিন্যাটাল স্ক্রিনিং করিয়ে নিন। গর্ভের সন্তান থ্যালাসেমিয়ায় আক্রান্ত হলে ঝুঁকি এড়াতে নিজেরা সিদ্ধান্ত নিতে পারবেন।
ইন ভিট্রো ফার্টিলাইজেশনের মাধ্যমে থ্যালাসেমিয়ামুক্ত ভ্রূণ মাতৃগর্ভে প্রতিস্থাপন করা যায়।
তবে কি রক্ত পরিসঞ্চালনই এ রোগের একমাত্র চিকিৎসা? মোটেই নয়। থ্যালাসেমিয়ায় আক্রান্ত রোগীর রক্তকণিকা ভেঙে যায়, অস্থিমজ্জায় সঠিকভাবে রক্ত তৈরি হতে পারে না। রক্তশূন্যতা হয়। আর এ রক্তশূন্যতার পেছনে রক্তের হিমোগ্লোবিনের আলফা ও নন–আলফা চেইনের ভারসাম্যহীনতা প্রধান কারণ। সুখবর হলো, বর্তমানে দক্ষ একজন রক্তরোগ বিশেষজ্ঞ চিকিৎসকের তত্ত্বাবধানে আধুনিক ও উন্নত চিকিৎসার মাধ্যমে থ্যালাসেমিয়া রোগীর এই চেইন ভারসাম্যহীনতা রোধ করা সম্ভব। ফলে রক্ত পরিসঞ্চালন–নির্ভর রোগীর একটি বড় অংশের এখন আর রক্ত পরিসঞ্চালনের দরকার পড়ে না।
থ্যালাসেমিয়া রোগীর ক্ষেত্রে রক্ত পরিসঞ্চালন হলো ‘ডাবল ব্লেডেড সোর্ড’-এর মতো। অপ্রয়োজনীয় রক্ত পরিসঞ্চালন আ্যলোইমিউনাইজেশন, শরীরে আয়রন জমা, হার্ট ফেইলিউর, লিভার ফেইলিউর, বৃদ্ধি ব্যাহত হওয়া, হরমোন রোগসহ আরও অনেক জটিল সমস্যার কারণ হতে পারে। তাই একজন রক্তরোগ বিশেষজ্ঞের পরামর্শ ব্যতীত অপ্রয়োজনে থ্যালাসেমিয়া রোগীর রক্ত পরিসঞ্চালন না করা ভালো।
দুই উপায়ে এ রোগ থেকে মুক্তি লাভ সম্ভব।
১. জিন থেরাপি: যা এখনো বাংলাদেশে শুরু হয়নি।
২. আ্যলোজেনিক স্টেমসেল ট্রান্সপ্ল্যান্ট: এ পদ্ধতিতে থ্যালাসেমিয়া থেকে সম্পূর্ণভাবে মুক্তি লাভ সম্ভব। ঢাকা মেডিকেল কলেজ হাসপাতালের হেমাটোলজি ও বোনম্যারো ট্রান্সপ্ল্যান্ট বিভাগে সফলভাবে অত্যন্ত কম খরচে অ্যালোজেনিক স্টেমসেল ট্রান্সপ্লান্ট হয়েছে। থ্যালাসেমিয়ায় আক্রান্ত রোগীর রোগের অন্তর্নিহিত কারণ, জটিলতা পুঙ্খানুপুঙ্খভাবে নিরূপণ করে চিকিৎসা গ্রহণ করলে এ রোগ সম্পূর্ণ নিয়ন্ত্রণ, এমনকি নির্মূল করাও সম্ভব।